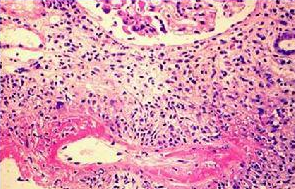

如何才能預防性病性淋巴肉芽腫呢?齊齊哈爾?現代專家為您介紹:
一、加強健康教育,避免婚外性接觸,防止不正常的性行為。患者在一切癥狀痊愈之前要禁止性交。
二、患者的性伴,如果在患者出現癥狀前30天內與患者有過接觸,則必須進行檢查和治療。
三、為預防患者疾病復發,用藥應注意早使用、用量足和時間長,一般來說,無論使用哪種治療藥物,在服藥第3周時都會基本痊愈,但此時不應停藥,應繼續服藥,但劑量可以降低,有些病人甚至需經2-3個療程的治療,這樣就不大會復發。
四、要隨時對病損處的分泌物及其污染品進行處理。70%乙醇、20%氯胺可將衣原體在短時間內滅活。 齊齊哈爾?現代男科醫院是一家全新致力于男性健康事業,以男科疾病治療為特色,前列腺疾病、男性生理功能障礙、泌尿生殖感染、男性生殖整形為龍頭的融國際化、專業化、規范化、人本化為一體的現代化男科醫院。
齊齊哈爾?現代男科醫院將始終秉承“誠信醫療,科技興院”的行醫宗旨,從掛號、檢驗、治療、藥品等各環節,嚴格執行國家的統一收費標準, 明碼標價,同時,醫院推行全面質量管理,建立健全質量保證體系,做好從接診到治療完畢全過程、全方位的保障服務,使患者真正享受到完整、優質、高效的醫療服務。
【友情提示】為了方便患者及有須要的人更好的了解所患疾病相關信息,齊齊哈爾?現代特別開設專家免費在線咨詢服務,由權威男科專家在線為您解答相關疾病問題,根據病情提供最專業治療方案,并為您的隱私保密。






































